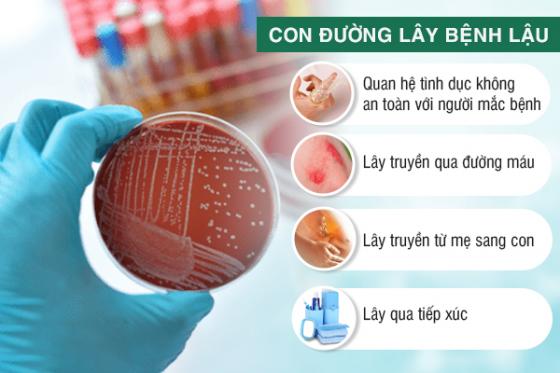
Bệnh lậu lây truyền như thế nào.jpg

Bệnh Lậu Ở Nữ: Triệu Chứng, Nguyên Nhân Và Hướng Điều Trị
Bệnh lậu là một trong những căn bệnh lây truyền qua đường tình dục phổ biến, đặc biệt là ở phụ nữ. Tuy nhiên, bệnh này thường không dễ nhận ra ở giai đoạn đầu, bởi triệu chứng có thể rất mờ nhạt và dễ bị nhầm lẫn với các bệnh phụ khoa khác. Chính vì vậy, việc nhận diện sớm các dấu hiệu bệnh lậu ở nữ là vô cùng quan trọng để có biện pháp điều trị kịp thời, tránh những biến chứng nguy hiểm.
BỆNH LẬU VÀ NGUYÊN NHÂN GÂY BỆNH Ở NỮ GIỚI
Bất kỳ ai, ở độ tuổi nào cũng có thể bị bệnh lậu. Tuy nhiên bệnh xảy ra nhiều ở lứa tuổi có hoạt động tình dục mạnh. Nữ giới có nguy cơ cao mắc lậu nếu tiếp xúc với nguồn bệnh. Bệnh lậu do vi khuẩn Neisseria gonorrhoeae gây ra, và có thể lây truyền qua các con đường sau:
➣ Quan hệ tình dục không an toàn với người mắc bệnh (bao gồm cả quan hệ tình dục qua miệng, hậu môn hoặc âm đạo).
➣ Lây truyền qua đường máu: Nếu bạn được nhận máu từ người bệnh có vi khuẩn lẩu, hoặc sử dụng chung bơm kim tiêm với người bệnh thì khả năng lây nhiễm là rất cao.
➣ Lây truyền từ mẹ sang con trong quá trình mang thai hoặc sinh thường qua đường âm đạo.
➣ Lây qua tiếp xúc với dịch mủ của người bệnh như khi sử dụng chung đồ dùng cá nhân (khăn tắm, bồn tắm, quần lót...)
[Kết nối với chuyên gia chuyên khoa bằng cách NHẤP VÀO KHUNG bên dưới]
NHẬN BIẾT CÁC DẤU HIỆU BỆNH LẬU Ở NỮ GIỚI
Ở nữ giới, các triệu chứng của bệnh lậu thường xuất hiện sau 3-6 ngày. Các biểu hiện lậu có thể khác nhau, cũng có thể không hiện rõ, nhưng có một số biểu hiện bệnh lậu phổ biến mà bạn cần lưu ý. Dưới đây là một số dấu hiệu và triệu chứng thường gặp ở nữ giới mắc bệnh lậu:
Dịch tiết âm đạo bất thường: Khí hư ra nhiều, có màu vàng hoặc xanh, kèm mùi hôi khó chịu.
Tiểu buốt, tiểu rát, tiểu nhiều lần: Cảm giác đau rát khi đi tiểu, đôi khi có lẫn máu trong nước tiểu.
Đau bụng dưới hoặc đau vùng chậu: Cảm giác đau âm ỉ hoặc dữ dội, đặc biệt là khi quan hệ tình dục.
Chảy máu âm đạo bất thường: Ra máu giữa kỳ kinh hoặc sau khi quan hệ.
Sốt cao, mệt mỏi, ớn lạnh, chán ăn: Biểu hiện toàn thân do vi khuẩn lậu tấn công lan rộng, làm suy giảm sức đề kháng.
▶▶ LỜI KHUYÊN: Nếu bạn nghi ngờ mình bị nhiễm bệnh lậu, quan trọng là nên tham khảo ý kiến của bác sĩ hoặc chuyên gia y tế. Họ có thể đưa ra đánh giá chính xác và cung cấp cách chữa bệnh lậu ở nữ giới phù hợp.
BỆNH LẬU NỮ GIỚI NGUY HIỂM NHƯ THẾ NÀO?
Bệnh lậu không được phát hiện và điều trị kịp thời có thể dẫn đến nhiều biến chứng nguy hiểm:
✚ Vô sinh - Hiếm muộn: Bệnh lậu có thể dẫn đến viêm vùng chậu (PID), có thể gây tắc vòi trứng, dẫn đến vô sinh hoặc hiếm muộn.
✚ Ảnh hưởng đến thai nhi: Phụ nữ mang thai mắc bệnh lậu có nguy cơ sảy thai, sinh non, hoặc sinh con bị viêm kết mạc, dẫn đến mù lòa.
✚ Viêm nhiễm đường sinh dục: Bệnh lậu có thể gây viêm âm đạo, viêm cổ tử cung và viêm tử cung, dẫn đến các vấn đề nghiêm trọng về sức khỏe sinh sản.
✚ Nhiễm trùng máu: Vi khuẩn lậu có thể lan ra toàn thân, gây nhiễm trùng máu, viêm khớp, hoặc viêm màng não, thậm chí có thể dẫn đến tử vong nếu không được điều trị kịp thời.
✚ Lây nhiễm cho bạn tình và người thân: Bệnh lậu lây truyền nếu quan hệ không an toàn, dùng chung đồ cá nhân với người bệnh, tiếp xúc qua vết thương hở,...
[Đừng bỏ lỡ ưu đãi giới hạn - Đặt lịch khám trước để được áp dụng ngay!]
CÁCH CHỮA BỆNH LẬU Ở NỮ GIỚI
Điều trị bệnh lậu ở nữ hiệu quả thì người bệnh cần đi thăm khám tại các cơ sở chuyên khoa. Bác sĩ sẽ căn cứ vào nguyên nhân bệnh cũng như tình trạng mức độ bệnh để đưa ra phương pháp phù hợp. Bao gồm:
✔ Điều trị bằng thuốc
Sử dụng thuốc kháng sinh để điều trị bệnh lậu là phương pháp được áp dụng cho những trường hợp bệnh lậu không biến chứng, khi bệnh còn nhẹ mới phát bệnh.
➪Tuy nhiên việc dùng thuốc phải tuân theo những hướng dẫn, chỉ định của các bác sĩ, người bệnh không nên tự ý mua thuốc về để điều trị.
✔ Phương pháp điều trị ngoại khoa
Hiện nay, kỹ thuật phục hồi gen DHA là phương pháp kỹ thuật tiên tiến trên thế giới, đem lại hiệu quả tích cực trong công tác điều trị bệnh lậu. Phương pháp này đã khắc phục được những nhược điểm của phương pháp truyền thống, được chuyên gia đánh giá cao.
Kỹ thuật này cho phép phân tích và kiểm tra hoạt động, mức độ gây hại, viêm nhiễm chéo của vi khuẩn gây bệnh, từ đó đưa ra những phương án điều trị phù hợp, tiêu diệt lậu cầu khuẩn, loại bỏ hết khuẩn lậu. Đồng thời tăng cường hệ miễn dịch để hạn chế bệnh tái lại, sức khỏe sớm hồi phục.
Ưu điểm của kỹ thuật phục hồi gen DHA:
✔ Xác định chính xác mầm bệnh, nâng cao hiệu quả, tránh sai sót.
✔ Thời gian điều trị ngắn và phục hồi bệnh nhanh
✔ Điều trị hiệu quả, an toàn, không đau, không để lại sẹo
✔ Hỗ trợ cơ thể nâng cao sức đề kháng, ngừa tối đa khả năng tái lại.
Nhấp VÀO ĐÂY để biết chi phí điều trị bệnh lậu bao nhiêu?
PHÒNG KHÁM ĐA KHOA BÌNH DƯƠNG: ĐỊA CHỈ TIN CẬY ĐIỀU TRỊ BỆNH LẬU UY TÍN
Nếu bạn nghi ngờ mình mắc bệnh lậu hoặc có dấu hiệu bất thường, hãy đến ngay Phòng khám Đa khoa Bình Dương để được thăm khám và điều trị kịp thời. Phòng khám sở hữu đội ngũ bác sĩ chuyên khoa giỏi, có nhiều năm kinh nghiệm trong điều trị bệnh lậu và các bệnh xã hội khác.
Đây là phòng khám đã được Sở y tế cấp phép hoạt động nhận được sự tin tưởng, đáp ứng các tiêu chí của một phòng khám chất lượng:
Có đội ngũ y bác sĩ được đào tạo kiến thức bài bản, có giấy phép hành nghề, có trình độ và chuyên môn cao.
Cơ sở vật chất, trang thiết bị chất lượng, các thiết bị máy móc được phòng khám đưa vào sử dụng đều được nhập khẩu từ các nước tiên tiến mang lại độ chính xác và an toàn cao.
Chi phí công khai, minh bạch được niêm yết theo quy định, mọi chi phí sẽ được thông báo cụ thể và rõ ràng với người bệnh.
Thủ tục đăng ký nhanh gọn, bảo mật thông tin và hồ sơ người bệnh.
Phòng khám mở cửa từ 8h sáng đến 18h tối, giúp bạn dễ dàng sắp xếp thời gian đến khám và điều trị.
>> Nhấp vào đây đặt lịch nhận ưu đãi “khủng” <<
Bệnh lậu ở nữ có thể gây ra nhiều biến chứng nguy hiểm ảnh hưởng đến sức khỏe sinh sản và cuộc sống. Vì vậy, nếu bạn gặp phải bất kỳ dấu hiệu nào của bệnh lậu, đừng chần chừ, hãy đến ngay cơ sở y tế uy tín để được thăm khám và điều trị kịp thời. Chăm sóc sức khỏe của bạn ngay từ hôm nay để tránh những hậu quả đáng tiếc sau này !
CÂU HỎI THƯỜNG GẶP VỀ BỆNH LẬU Ở NAM VÀ NỮ GIỚI
❄ Nguyên nhân gây bệnh lậu là gì?
❄ Dấu hiệu bệnh lậu ở nam giới là gì?
❄ Dấu hiệu bệnh lậu ở nữ giới là gì?
❄ Bệnh lậu có chữa khỏi hoàn toàn không?
❄ Bao lâu sau khi quan hệ có thể phát hiện bệnh lậu?
❄ Bị bệnh lậu nên khám ở đâu tại Bình Dương?
Gói khám nam khoa
- 1 Bệnh nhân 1 bác sĩ
- Thông tin bảo mật
Khám sinh lý nam giới
- Bác sĩ chuyên môn cao
- Trang thiết bị đạt chuẩn bộ Y tế
Gói khám bệnh xã hội
- Tận tâm, nhiệt tình
- Chăm sóc chu đáo
Ưu đãi giảm
- Phí điều trị
PHÒNG KHÁM ĐẠT CHUẨN BỘ Y TẾ
quy trình thăm khám

0933.833.115
Đặt lịch
Tư vấn
Zalo